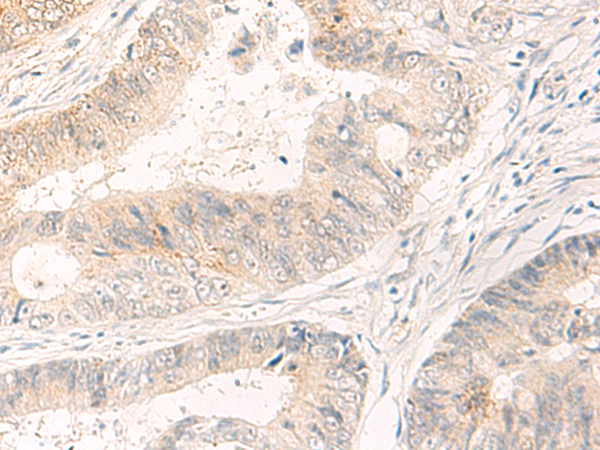

|
Background: |
May be involved in the trafficking and exocytosis of secretory vesicles in non-neuronal tissues. Is Ca2+-independent. |
|
Applications: |
ELISA, IHC |
|
Name of antibody: |
SYT16 |
|
Immunogen: |
Synthetic peptide of human SYT16 |
|
Full name: |
synaptotagmin 16 |
|
Synonyms: |
yt14r; SYT14L; syt14r; Strep14; CHR14SYT |
|
SwissProt: |
Q17RD7 |
|
ELISA Recommended dilution: |
5000-10000 |
|
IHC positive control: |
Human colorectal cancer and Human tonsil |
|
IHC Recommend dilution: |
25-100 |

購物車
購物車 幫助
幫助
 021-54845833/15800441009
021-54845833/15800441009
